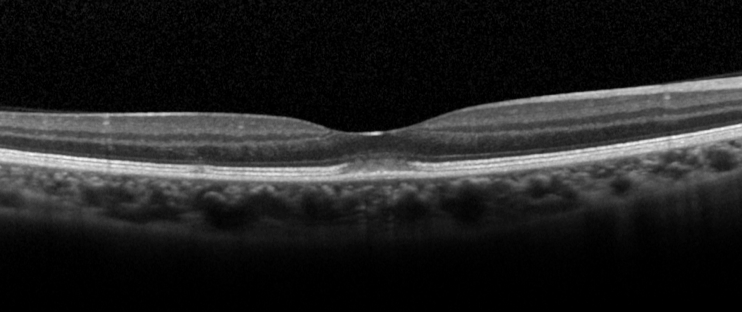

Acute Retinal Pigment Epitheliitis (Krill Disease)
All content on Eyewiki is protected by copyright law and the Terms of Service. This content may not be reproduced, copied, or put into any artificial intelligence program, including large language and generative AI models, without permission from the Academy.
Disease Entity
Acute retinal pigment epitheliitis (ARPE), also known as Krill’s disease, is a rare inflammatory disease of the retina.
Disease
ARPE is a rare, idiopathic, self-limiting inflammatory disease of the retina that commonly affects young adults.[1][2][3] It was first described by Alex E. Krill and August F. Deutman in six patients in 1972.[4] These six patients, consisting of three males and three females, were of the ages of 16, 18, 22, 43, 45, and 46 years.[4] Krill and Deutman described the retinal lesions to be clusters of small round, dark gray spots surrounded by circular whitish depigmented zones located in the macula.[4] The condition had an acute onset with fairly rapid resolution in 6 to 12 weeks, and recovery to normal or almost normal vision was achieved in all six patients.[4]
Although in previous studies, it was believed that the primary site of inflammation was located at the retinal pigment epithelium (RPE), recent studies using spectral-domain optical coherence tomography suggested the primary site of inflammation is located at the interdigitation zone i.e. the contact between photoreceptors and RPE instead of the RPE itself.[5]
Epidemiology
ARPE typically affects young healthy adults between the age of 20 and 50 years.[1] It is rare and the incidence is unknown. Males and females are equally likely to be affected.[1] In a case series of 18 patients in South Korea, the male-to-female ratio was 6:4.[1] No racial predisposition has been described.
Etiology and Pathophysiology
The etiology and pathophysiology are unknown. Similar to many white dot syndromes, flu-like symptoms have been reported to occur before onset of ARPE, suggesting viral infection may play a role in the pathogenesis.[6] However, a case series of 18 patients showed that only 17% of patients had prodromal influenza-like symptoms before onset of the disease.[1]
Diagnosis

History
Patients typically present with acute painless loss of vision or central scotoma. Usually, only one eye is affected;[1] however, bilateral involvement may also occur occasionally.[4][6] Prodromal influenza-like symptoms occur in around 17% of patients at 1-2 weeks before the onset of symptoms.[1]
Physical Examination
The presenting visual acuity is usually around 20/40 and can range from 20/30 to 20/100.[1] Amsler grid shows a central scotoma.[5] The anterior segment examination is typically unremarkable.[5] Signs of intraocular inflammation are absent.[5] The fundus examination characteristically shows fine pigment stippling in the macula surrounded by a hypopigmented halo (Figures 1 and 2).[4][5][7] A few white dots may also be seen in the macula in the extrafoveal region.[5][8]
Investigation
Optical coherence tomography
Optical coherence tomography (OCT) is the investigation of choice for diagnosis and follow-up of patients. The characteristic OCT feature is a dome-shaped hyperreflective lesion at the photoreceptor outer segment layer disrupting the ellipsoid zone and interdigitation zone (Figure 3).[1][5] The outer nuclear layer may be involved by the hyperreflective lesion.[2][5] In the early phase of the disease (within 2 days of symptoms onset), upward displacement of the external limiting membrane and mild transient thickening of the RPE/Bruch’s complex can be seen.[5]
En-face OCT may show a cockade-like lesion with a hypo-reflective centre and hyper-reflective border at the level of ellipsoid zone, and a hyper-reflective punctate lesion at the level of outer nuclear layer in the fovea.[6]
Fluorescein angiography
Fluorescein angiography (FA) shows hyperfluorescence at the fovea due to a transmission window defect in 83% of cases.[1][9][10] Leakage of fluorescein dye is absent.[1][11] The FA can be unremarkable in some patients.[1]
Indocyanine green angiography
In the early phase, ICGA is typically unremarkable.[1] In the mid-to-late phase, ICGA may show a small patch of hyperfluorescence in the fovea (1 in 6 cases) or a halo-like hyperfluorescent lesion (4 in 6 cases).[1] ICGA, like FA, can also be unremarkable in some patients.[1][5]
Fundus autofluorescence
Fundus autofluorescence (FAF) may show slight increased autofluorescence in the foveal center and in the areas corresponding to the hypopigmented white dots.[5][8] FAF may be unremarkable in some patients.[6]
Multifocal electroretinogram
Multifocal electroretinogram shows depression of central amplitudes.[12]
Electro-oculogram
Electrooculogram may show a decreased Arden ratio.[4][12]
Visual field test
Visual field test shows decreased threshold sensitivity in the central region.[13]
Clinical Diagnosis
The diagnosis is based on typical presentation and the characteristic fundal feature of pigment stippling at fovea surrounded by a hypopigmented halo. OCT helps to support the diagnosis. Other investigations such as FA and ICGA are helpful to rule out other conditions.
Differential diagnoses
Multiple evanescent white dot syndrome
Multiple evanescent white dot syndrome (MEWDS) is an inflammatory retinal disease in the family of white dot syndromes. Similar to ARPE, MEWDS typically affects young adults and is self-limiting.[14] The pathognomonic orange foveal granularity in MEWDS may resemble the foveal pigment stippling in ARPE. However, MEWDS typically shows a more extensive retinal involvement where multiple whitish dots at the level of outer retina can be seen extending from posterior pole to equator.[14] FFA and ICGA are useful to differentiate MEWDS from ARPE. In MEWDS, FFA shows a punctate hyperfluorescence in a wreath-like configuration, and ICGA shows multiple hypofluorescent dots that out-number the visible lesions seen ophthalmologically and on FFA.[14]
Acute macular neuroretinopathy
Similar to ARPE, patients with acute macular neuroretinopathy (AMNR) present with sudden onset of central or paracentral scotoma.[15] AMNR appears as reddish-brown, wedge-shaped lesions in the paracentral region in a tear-drop configuration pointing towards the fovea.[15] The pathogenesis was postulated to be due to ischemia of the deep retinal capillary plexus.[15] Therefore, OCT of AMNR shows hyper-reflective plaques at the border of outer plexiform layer and outer nuclear layers,[15] whereas in ARPE the hyper-reflective lesion was mainly located at the photoreceptor outer segment layer.[5]
Acute idiopathic maculopathy
Similar to ARPE, acute idiopathic maculopathy (AIM) typically affects young adults and presents as acute unilateral visual loss.[16] OCT is useful to differentiate AIM from ARPE. OCT of AIM shows swelling of outer retina with presence of hyper-reflective exudation and hypo-reflective fluid in the subretinal space,[17] whereas OCT of ARPE shows a dome-shaped hyper-reflective lesion at the photoreceptor outer segment layer disrupting the ellipsoid zone and interdigitation zone.
Solar retinopathy
Solar retinopathy appears as yellowish dot in the fovea.[18] OCT may show disruption of the outer retinal layers.[18] Diagnosis depends on a history of direct sun-gazing or eclipse viewing and bilateral foveal involvement.
Management

General treatment
No treatment is necessary because of the self-limiting nature of the disease.[1] Spontaneous resolution of the lesion and recovery of vision occur in all patients without treatment.[1] Use of oral steroid does not shorten the course of recovery.[5] In a case series of 4 patients with ARPE, the 3 patients who were treated with oral steroid had slower recovery of vision than the patient without any treatment.[5]
Medical follow up
Patients should be followed with serial visual acuity tests, fundal examinations and OCT. Complete recovery of visual acuity, fundal abnormalities and OCT retinal bands is expected within weeks.
During recovery, OCT shows a typical pattern where the inflammatory lesion reduces in height and the retinal layers restore in order from inner to outer layers (Figure 4). The recovery involves a sequence of: (1) decrease in height of OCT hyper-reflective lesion and the displaced external limiting membrane returned to its normal position with irregularity, (2) complete disappearance of the hyper-reflective lesion, (3) restoration of external limiting membrane, (4) restoration of ellipsoid zone, and (5) restoration of interdigitation zone (Figure 4).[5] Occasionally, there is a persistent defect in the OCT ellipsoid zone associated with incomplete visual recovery.[19]
Prognosis
The prognosis is excellent. Complete recovery of visual acuity to 20/20 occurred in 89% of patients within 2 months.[1] However, incomplete visual recovery for more than 1 year has been described.[1] Poor prognostic factors included poor baseline visual acuity of <20/70 and extensive retinal involvement involving the outer nuclear layer.[1] Recurrences are exceedingly rare. [20]
Additional Resources
- American Academy of Ophthalmology. Acute Retinal Pigment Epitheliitis. Focal Points - Excerpt. https://www.aao.org/education/focalpoints Accessed 25 September 2024.
References
- ↑ 1.00 1.01 1.02 1.03 1.04 1.05 1.06 1.07 1.08 1.09 1.10 1.11 1.12 1.13 1.14 1.15 1.16 1.17 1.18 1.19 Cho HJ, Han SY, Cho SW, Lee DW, Lee TG, Kim CG, Kim JW. Acute retinal pigment epitheliitis: spectral-domain optical coherence tomography findings in 18 cases. Invest Ophthalmol Vis Sci 2014;55(5):3314-9.
- ↑ 2.0 2.1 Baillif S, Wolff B, Paoli V, Gastaud P, Mauget-Faysse M. Retinal fluorescein and indocyanine green angiography and spectral-domain optical coherence tomography findings in acute retinal pigment epitheliitis. Retina 2011;31(6):1156-63.
- ↑ Fouad YA, Cicinelli MV, Marchese A, Casalino G, Jampol LM. Revisiting acute retinal pigment epitheliitis (Krill disease). Surv Ophthalmol. 2024 Nov-Dec;69(6):916-923. doi: 10.1016/j.survophthal.2024.07.003.
- ↑ 4.0 4.1 4.2 4.3 4.4 4.5 4.6 Krill AE, Deutman AF. Acute retinal pigment epitheliitus. Am J Ophthalmol. 1972;74:193-205.
- ↑ 5.00 5.01 5.02 5.03 5.04 5.05 5.06 5.07 5.08 5.09 5.10 5.11 5.12 5.13 5.14 5.15 5.16 5.17 Iu LPL, Lee R, Fan MCY, Lam WC, Chang RT, Wong IYH. Serial Spectral-Domain Optical Coherence Tomography Findings in Acute Retinal Pigment Epitheliitis and the Correlation to Visual Acuity. Ophthalmology 2017;124(6):903-9.
- ↑ 6.0 6.1 6.2 6.3 De Bats F, Wolff B, Mauget-Faysse M, Scemama C, Kodjikian L. B-scan and "en-face" spectral-domain optical coherence tomography imaging for the diagnosis and followup of acute retinal pigment epitheliitis. Case Rep Med 2013;2013:260237.
- ↑ Merkoudis N, Granstam E. Acute retinal pigment epitheliitis: optical coherence tomography findings at onset and follow-up. Acta Ophthalmol 2013;91(1):e84-5.
- ↑ 8.0 8.1 Aydogan T, Guney E, Akcay BI, Bozkurt TK, Unlu C, Ergin A. Acute retinal pigment epitheliitis: spectral domain optical coherence tomography, fluorescein angiography, and autofluorescence findings. Case Rep Med 2015;2015:149497.
- ↑ Hall EF, Ahmad B, Schachat AP. Spectral-domain optical coherence tomography findings in acute retinal pigment epitheliitis. Retin Cases Brief Rep 2012;6(3):309-12.
- ↑ Hsu J, Fineman MS, Kaiser RS. Optical coherence tomography findings in acute retinal pigment epitheliitis. Am J Ophthalmol 2007;143(1):163-5.
- ↑ Moroz I, Alhalel A. Resolution of retinal pigment epitheliitis-optical coherence tomography findings. Retin Cases Brief Rep 2008;2(2):101-2
- ↑ 12.0 12.1 Gundogan FC, Diner O, Tas A, Ilhan A, Yolcu U. Macular function and morphology in acute retinal pigment epithelitis. Indian J Ophthalmol 2014;62:1156-8.
- ↑ Kim JW, Jang SY, Park TK, Ohn YH. Short-term clinical observation of acute retinal pigment epitheliitis using spectral-domain optical coherence tomography. Korean J Ophthalmol 2011;25(3):222-4.
- ↑ 14.0 14.1 14.2 dell'Omo R, Pavesio CE. Multiple evanescent white dot syndrome (MEWDS). Int Ophthalmol Clin 2012;52(4):221-8.
- ↑ 15.0 15.1 15.2 15.3 Bhavsar KV, Lin S, Rahimy E, Joseph A, Freund KB, Sarraf D, Cunningham ET, Jr. Acute macular neuroretinopathy: A comprehensive review of the literature. Surv Ophthalmol 2016;61(5):538-65.
- ↑ Hoang QV, Strauss DS, Pappas A, Freund KB. Imaging in the diagnosis and management of acute idiopathic maculopathy. Int Ophthalmol Clin 2012;52(4):263-8.
- ↑ Srour M, Querques G, Rostaqui O, Souied EH. Early spectral-domain optical coherence tomography findings in unilateral acute idiopathic maculopathy. Retina 2013;33(10):2182-4.
- ↑ 18.0 18.1 Wu CY, Jansen ME, Andrade J, Chui TYP, Do AT, Rosen RB, Deobhakta A. Acute Solar Retinopathy Imaged With Adaptive Optics, Optical Coherence Tomography Angiography, and En Face Optical Coherence Tomography. JAMA Ophthalmol 2018;136(1):82-5.
- ↑ Cho HJ, Lee DW, Kim CG, Kim JW. Spectral domain optical coherence tomography findings in acute retinal pigment epitheliitis. Can J Ophthalmol 2011;46(6):498-500.
- ↑ Roy R, Saurabh K, Thomas NR. MULTICOLOR IMAGING IN A CASE OF ACUTE RETINAL PIGMENT EPITHELIITIS. Retin Cases Brief Rep. 2021 Jan 1;15(1):45-48. doi: 10.1097/ICB.0000000000000726. PMID: 29474220.


